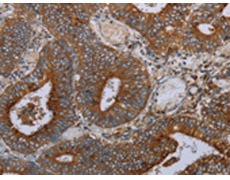
一抗

中文名稱(chēng):兔抗MAFF多克隆抗體
|
Background: |
The protein encoded by this gene is a basic leucine zipper (bZIP) transcription factor that lacks a transactivation domain. It is known to bind the US-2 DNA element in the promoter of the oxytocin receptor (OTR) gene and most likely heterodimerizes with other leucine zipper-containing proteins to enhance expression of the OTR gene during term pregnancy. The encoded protein can also form homodimers, and since it lacks a transactivation domain, the homodimer may act as a repressor of transcription. This gene may also be involved in the cellular stress response. Multiple transcript variants encoding two different isoforms have been found for this gene. |
|
Applications: |
ELISA, IHC |
|
Name of antibody: |
MAFF |
|
Immunogen: |
Synthetic peptide of human MAFF |
|
Full name: |
v-maf musculoaponeurotic fibrosarcoma oncogene homolog F |
|
Synonyms: |
U-MAF, hMafF |
|
SwissProt: |
Q9ULX9 |
|
ELISA Recommended dilution: |
1000-2000 |
|
IHC positive control: |
Human colon cancer and Human esophagus cancer |
|
IHC Recommend dilution: |
25-100 |

 購(gòu)物車(chē)
購(gòu)物車(chē) 幫助
幫助
 021-54845833/15800441009
021-54845833/15800441009